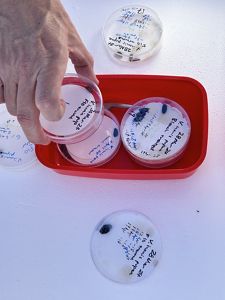
has been done to test the control of invasive wasps in New Zealand's South Island.

Controlling Invasive Wasps in New Zealand's South Island
The release of the hoverfly will be a significant step forward in reducing the invasive wasp population.

Efforts to reduce the wasp population in the northern regions of New Zealand’s South Island have taken a significant step forward with the release of the European hoverfly at two sites in Marlborough and Tasman.
Manaaki Whenua – Landcare Research scientist Dr. Bob Brown released the first European hoverflies on a farm in Rai Valley with support from local iwi, Marlborough District Council and the Kotahitanga mō te Taiao Alliance. More hoverflies were released at a site in Wainui, Golden Bay the following week, with the release attended by Tasman District Council, local iwi and Kotahitanga mō te Taiao Alliance. Both sites were assessed for potential cultural impacts by iwi/hapu with ties to the area.
The journey to the release has been a long one, involving a number of people committed to controlling wasps and reducing their impact on native birds and insects, as well as ensuring that any biocontrol agents released were thoroughly tested and approved by the Environmental Protection Agency (EPA).

In February 2021, the EPA approved the import and release of two biocontrol agents, targeted at the invasive common wasp (Vespula vulgaris) and German wasp (Vespula germanica). From there, Metoecusparadoxus (a wasp nest beetle) and Volucella inanis (a hoverfly) were imported to New Zealand from the UK reared at Manaaki Whenua and then provided for release.
Both the German and common wasp are very destructive invasive pests that cost New Zealand up to $130 million annually in damages and management. They attack a wide variety of arthropods including honeybees, butterflies, flies and spiders, and will also scavenge for protein from animal carcasses and dustbins. They have detrimental effects on normal ecosystem functioning, food webs and the behaviour of native birds. The predation rate of wasps on native invertebrates is believed to be so high that some species are at risk of extinction.
As a natural enemy focused solely on Vespula wasps, there is robust evidence it is safe to release the hoverfly in New Zealand, and if successful, it will have positive impacts on the native plants and animals and the honey industry. It will also be a huge relief to those who enjoy the outdoors or work on the land. Consultation with Kotahitanga mō te Taiao partners, especially top of the South Iwi, and with other interested organisations has been carried out and biosecurity concerns met.

Ruihana Smith (Ngāti Kuia) attended the Rai Valley release and said that careful consideration was undertaken to introduce hoverflies in an attempt to bring back the mauri, the life force, of the environment. “A lot of thought has gone into this release—we’ve undertaken a cultural effects assessment and found that there’s a high potential of having a really positive outcome for Te Taiao. We see it as a step forward in restoring and enhancing the mauri and life force of Te Hoiere.”
Biocontrol agents such as the hoverfly are brought in to reduce the vigour and viability of widespread pests and are seen as a more sustainable option than pesticides. The adult female hoverfly enters the wasp nest and lays eggs in larval cells. Once hatched, the fly larvae feed on wasp larvae and pupae. This is not an eradication technique but rather a way to bring populations of a target species down to a less harmful level.
Dr. Brown said the next step is to monitor progress and work towards further releases to build a sustainable population. “We’ve chosen sites that are a good distance apart in case unforeseen natural disasters destroy any of the sites, so we have a backup. We’ll be coming back to check on them next summer, before we release the next batch, to see how they are doing.” It is not unusual to require several releases of a biological control agent for it to successfully establish in the area.
Any noticeable success around the hoverfly releases may not be apparent for at least 18 months, and it is unlikely that vespid wasps will be eradicated from the district altogether. However, it is hoped that the hoverfly will adapt to its new environment and reduce wasp densities in the Top of The South.
Debs Martin, Programme Manager for the Kotahitanga mō te Taiao Alliance said that the hoverfly releases are a significant step in controlling wasps and reducing their impact on native birds and insects. “We want the forest to be alive with the sounds of birdsong, not the hum of wasps. Wasps are a huge regional problem and access to the back country to control them is often impossible.
“The hoverfly has the potential to control them at landscape scale, even in those hard-to-reach places. The Kotahitanga mō te Taiao Alliance is proud to support the many agencies and people who have worked together to make this release possible and are pleased to have brought The Nature Conservancy Aotearoa New Zealand funding to the programme."
This work is a collaboration between Manaaki Whenua – Landcare Research, Tasman District Council, and the Vespula Action Group, as part of a Ministry for Primary Industries Sustainable Farming Fund. Support has also been provided by Manaaki Whenua's Strategic Science Investment Fund (SSIF) and The Nature Conservancy Aotearoa New Zealand to facilitate the releases as part of the Kotahitanga mō te Taiao strategy.



